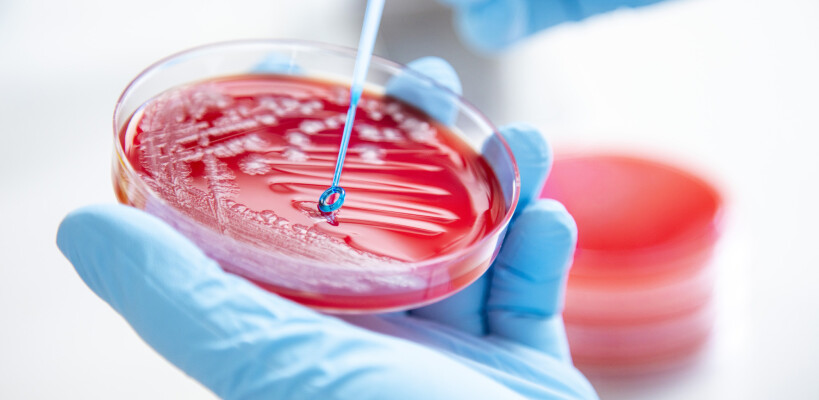
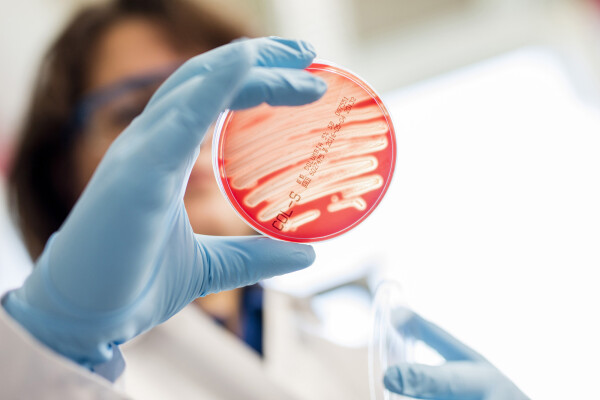

Fotograaf: Mark van Stokkom
Mark van Stokkom

Uitgevoerde opdrachten: -
Mijn naam is Mark van Stokkom. Fotograaf sinds 1995.
Mijn specialiteit is het werken met mens en dier. Het in opdracht fotograferen van mensen heeft altijd een vorm van tijdsdruk.
De feedback die ik terugkrijg van mijn opdrachtgevers, is dat ze de omgang met mij altijd als zeer prettig en ontspannen ervaren.
Goede observatie in de ruimte, meedenkend en oog voor detail.